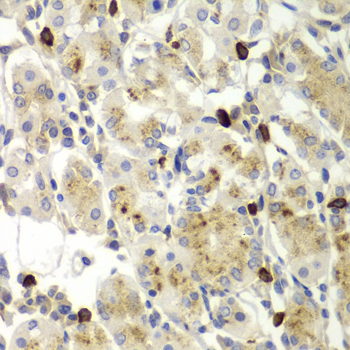

For quotations, please use our online quotation form, and you may also contact us by
service@kendallscientific.com
+1-888.733.6849 (Toll-free)
+1-617.299.7367 (Int’l))
+1-888.733.6849
Our customer service representatives are available 24 hours, Monday through Friday to assist you.| Reactivity | Human Mouse Rat |
| Tested applications | WB IHC |
| Recommended Dilution | WB 1:500 - 1:2000 IHC 1:100 - 1:200 |
| Calculated MW | 78kDa |
| Observed MW | Refer to Figures |
| Immunogen | A synthetic peptide of human MMP9 |
| Storage Buffer | Store at -20℃. Avoid freeze / thaw cycles. Buffer: PBS with 0.02% sodium azide, 50% glycerol, pH7.3. |
| Concentration | b |
| Synonym | CLG4B; GELB; MMP-9; |

Western blot analysis of extracts of mouse spinal cord cell lines, using MMP9 antibody.

Western blot analysis of extracts of various cell lines, using MMP9 antibody.
Immunohistochemistry of paraffin-embedded human gastric using MMP9 antibody at dilution of 1:100 (x400 lens).

Immunohistochemistry of paraffin-embedded mouse heart using MMP9 antibody.

Immunohistochemistry of paraffin-embedded mouse kidney using MMP9 antibody.

Immunohistochemistry of paraffin-embedded human stomach using MMP9 antibody.

Immunohistochemistry of paraffin-embedded mouse brain using MMP9 antibody.

Immunohistochemistry of paraffin-embedded mouse kidney using MMP9 antibody.

Immunohistochemistry of paraffin-embedded mouse stomach using MMP9 antibody.

Immunohistochemistry of paraffin-embedded human liver injury using MMP9 antibody.

Immunohistochemistry of paraffin-embedded mouse liver using MMP9 antibody.

Immunohistochemistry of paraffin-embedded mouse kidney using MMP9 antibody.

Immunohistochemistry of paraffin-embedded human liver injury using MMP9 antibody.

Immunohistochemistry of paraffin-embedded human esophagus using MMP9 antibody.

Immunohistochemistry of paraffin-embedded human stomach using MMP9 antibody.
The matrix metalloproteinases (MMPs) are a family of proteases that target many extracellular proteins including other proteases, growth factors, cell surface receptors and adhesion molecules (1). Among the family members, MMP-2, MMP-3, MMP-7 and MMP-9 have been characterized as important factors for normal tissue remodeling during embryonic development, wound healing, tumor invasion, angiogenesis, carcinogenesis and apoptosis (2-4). MMP activity correlates with cancer development (2). One mechanism of MMP regulation is transcriptional (5). Once synthesized, MMP exists as a latent proenzyme. Maximum MMP activity requires proteolytic cleavage to generate active MMPs by releasing the inhibitory propeptide domain from the full length protein (5).
N/A